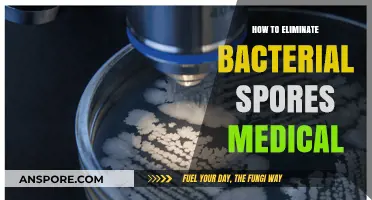
Effective Strategies to Eradicate Bacterial Spores in Medical Environments

Editing your Spore profile allows you to customize your in-game identity, showcase your creations, and personalize your experience within the Spore community. Whether you want to update your username, change your avatar, or manage your shared content, the process is straightforward and accessible through the game’s interface or the Spore website. By learning how to edit your profile, you can ensure your presence in the Spore universe reflects your creativity and style, making it easier to connect with other players and share your unique designs.
| Characteristics | Values |
|---|---|
| Platform | PC (Windows/Mac) |
| Game Version | Spore (Base Game/Galactic Adventures) |
| Profile Location | Documents\My Games\Spore\Saves (Windows) or ~/Documents/My Games/Spore/Saves (Mac) |
| File Extension | .package |
| Editing Tools | SporeMaster, Package Editor, or Hex Editor |
| Editable Elements | Creature appearance, abilities, traits, and saved games |
| Backup Requirement | Always back up .package files before editing |
| Compatibility | Edited profiles may not work across different game versions |
| Online Sharing | Edited profiles can be shared via Sporepedia or file transfer |
| Risks | Corrupting save files if edits are not done carefully |
| Community Resources | Spore Modding Community, Reddit (r/spore), and official forums |
Explore related products
What You'll Learn
- Changing Spore Profile Name: Modify your in-game name via Spore’s settings menu under profile options
- Updating Profile Picture: Replace default avatar with custom images using Spore’s built-in editor tools
- Editing Bio Information: Add or revise personal details in the profile description section for customization
- Managing Creations Visibility: Control which creations are public or private in your Spore profile
- Resetting Profile Data: Clear profile data and start fresh by resetting through game settings

Changing Spore Profile Name: Modify your in-game name via Spore’s settings menu under profile options
Your Spore profile name is your digital identity within the game's universe. It's how other players recognize you, and it can reflect your creativity, humor, or strategic intent. Fortunately, changing this name is a straightforward process, accessible directly through the game's settings.
To modify your in-game name, navigate to the Spores settings menu. This menu is typically found in the main interface, often represented by a gear icon or a similar symbol. Once inside, look for the profile options section. Here, you’ll find the field where your current profile name is displayed. Simply click on it, delete the existing text, and type in your new desired name. Be mindful of character limits, as some games restrict the length of profile names to ensure they fit within the game’s UI.
While the process is simple, there are a few practical tips to enhance your experience. First, consider the context of your new name. If you’re playing in a community or with friends, choose a name that’s memorable but not confusing. Avoid using special characters or symbols that might not display correctly across all platforms. Additionally, if you’re changing your name to align with a specific in-game strategy or role, ensure it reflects that purpose clearly.
One common caution is the frequency of name changes. Some games limit how often you can alter your profile name, either through cooldown periods or permanent locks after a certain number of changes. Check Spore’s specific policies to avoid unintended restrictions. If you’re unsure about a name, test it out in a less visible context before finalizing the change.
In conclusion, changing your Spore profile name is a quick and effective way to refresh your in-game identity. By following these steps and considering the practical tips, you can ensure your new name serves its purpose without unnecessary hassle. Whether you’re rebranding for fun or strategy, the process is designed to be user-friendly, allowing you to focus on what matters most—enjoying the game.
Does Sterilization Kill Spores? Unraveling the Science Behind Disinfection
You may want to see also

Updating Profile Picture: Replace default avatar with custom images using Spore’s built-in editor tools
Personalizing your Spore profile begins with ditching the generic avatar. The game’s built-in editor tools offer a surprisingly robust way to replace the default image with a custom creation, reflecting your unique style or in-game achievements. This process not only enhances your profile’s visual appeal but also serves as a creative outlet to showcase your design skills.
To start, access the Spore editor by navigating to the "My Spore Page" section within the game. Here, you’ll find the "Edit Profile" option, which includes a dedicated tab for managing your avatar. The editor interface is intuitive, allowing you to upload custom images directly from your device. Ensure your image meets the recommended dimensions (typically 256x256 pixels) for optimal display. Once uploaded, the editor provides basic tools to resize, crop, or adjust the image to fit seamlessly within the avatar frame.
While the editor is user-friendly, there are a few nuances to consider. For instance, transparency in PNG files can create interesting effects, but overly complex designs may appear cluttered in the small avatar space. Experiment with simpler, high-contrast images for better visibility. Additionally, Spore’s editor allows layering, enabling you to combine multiple images or add text for a more dynamic look. However, be mindful of file size limits, as larger images may slow down the upload process or fail to save.
The true value of customizing your avatar lies in its ability to tell a story. Whether it’s a creature you’ve meticulously designed, a symbol of your in-game faction, or a personal emblem, your profile picture becomes a visual signature. This small change can foster a stronger sense of identity within the Spore community, making your interactions more memorable. By leveraging the built-in editor tools, you transform a default placeholder into a canvas for self-expression, blending creativity with functionality.
Pollen vs. Spores vs. Sperm: Key Differences Explained
You may want to see also

Editing Bio Information: Add or revise personal details in the profile description section for customization
Your Spore profile is your digital calling card, a snapshot of your identity within the game’s universe. Editing your bio information allows you to craft a narrative that reflects your creativity, personality, or in-game achievements. Start by accessing your profile settings, typically found in the main menu under “Profile” or “Account.” Here, you’ll locate the bio or description section, a blank canvas waiting for your personal touch. Whether you’re a seasoned player or a newcomer, this section is your opportunity to stand out.
Consider what details will resonate with your audience. Are you a master creator known for intricate creatures? Mention your signature style or favorite creations. Do you excel in collaborative gameplay? Highlight your team-oriented approach. Keep it concise yet engaging—think of it as a tagline that captures your essence. For example, instead of simply stating, “I like making creatures,” try, “Architect of surreal ecosystems, blending biomechanics with fantasy.” This not only informs but intrigues.
Revising your bio isn’t just about adding details; it’s about refining your story. Periodically update it to reflect your evolving journey within the game. Did you recently achieve a milestone, like completing a challenging quest or unlocking a rare achievement? Add it to your bio to keep it current. However, avoid overcrowding—stick to 2-3 key points that define you. Think of it as curating a gallery, where each piece contributes to a cohesive narrative.
Practical tip: Use markdown or in-game formatting tools to make your bio visually appealing. Bold important phrases, italicize titles, or use bullet points for clarity. For instance, *“Specializes in: Creature Design | Space Exploration | Tribal Strategies”* is easier to scan than a dense paragraph. If the game allows, incorporate emojis or symbols sparingly to add personality without clutter.
Finally, remember that your bio is a reflection of your in-game identity, but it doesn’t have to be permanent. Experiment with different tones—humorous, mysterious, or straightforward—to see what feels authentic. The goal is to create a profile that not only informs but connects with fellow players. After all, in a game as creative as Spore, your bio is your first impression—make it count.
Do You Need an EA Account to Play Spore? Explained
You may want to see also
Explore related products

Managing Creations Visibility: Control which creations are public or private in your Spore profile
In the vast universe of Spore, your creations are your legacy, but not every masterpiece needs to be on display for all to see. Managing the visibility of your creations is a crucial aspect of curating your Spore profile, allowing you to control the narrative of your creative journey. Whether you're a seasoned Spore veteran or a newcomer, understanding how to toggle between public and private settings can significantly impact your experience.
The Power of Privacy: A Strategic Approach
Imagine crafting a unique creature, a top-secret project, or an experimental creation that's not quite ready for the spotlight. Here's where the private setting becomes your ally. By marking a creation as private, you retain full control over its exposure. This feature is particularly useful for creators who wish to refine their work without immediate public scrutiny. For instance, you might be designing a complex ecosystem, and making it private allows you to test and tweak without the pressure of public feedback. This strategic approach ensures that your creative process remains uninterrupted, fostering a more experimental and fearless environment.
Steps to Control Visibility:
- Access Your Profile: Begin by logging into your Spore account and navigating to your profile page. Here, you'll find a comprehensive overview of your creations.
- Select the Creation: Click on the specific creation you wish to modify. This could be a creature, building, vehicle, or any other Spore masterpiece.
- Edit Settings: Look for the visibility or privacy settings option, often represented by a small icon or a dropdown menu. Here, you can choose between 'Public' and 'Private'.
- Save Changes: After making your selection, ensure you save the changes. This simple step ensures your preferences are applied.
Public Display: Showcasing Your Masterpieces
On the flip side, making creations public is about sharing your artistic vision with the world. Public creations contribute to the vibrant Spore community, inspiring and engaging fellow players. When a creation is set to public, it becomes part of the Spore galaxy, available for others to discover, download, and even incorporate into their own games. This aspect of sharing fosters collaboration and can lead to exciting creative partnerships. For instance, a public creature design might catch the eye of a Spore filmmaker, leading to its feature in a popular Spore movie.
Best Practices for Visibility Management:
- Curate Your Portfolio: Treat your public creations as a portfolio, showcasing your best and most diverse work. Regularly update and rotate your public displays to keep your profile fresh and engaging.
- Engage with Feedback: Public creations often attract comments and ratings. Embrace this feedback as a valuable tool for growth, but also remember to maintain a healthy perspective, especially when dealing with constructive criticism.
- Experiment Freely: Utilize the private setting to encourage risk-taking and innovation. Without the pressure of public judgment, you can explore unconventional ideas and push the boundaries of your creativity.
In the realm of Spore, managing creation visibility is an art in itself, allowing you to navigate between personal expression and community engagement. By mastering these settings, you can tailor your Spore experience, ensuring that your creative journey is both fulfilling and under your control. This simple yet powerful feature empowers you to decide when to share your creations with the world and when to keep them as personal treasures.
How Do Bryophytes Disperse Spores? Exploring Their Unique Reproduction Methods
You may want to see also

Resetting Profile Data: Clear profile data and start fresh by resetting through game settings
Sometimes, a clean slate is the best way to reignite your creativity in *Spore*. Whether you’ve maxed out achievements, cluttered your profile with unwanted creations, or simply want to relive the early-game experience, resetting your profile data can be a refreshing option. This process wipes your saved progress, allowing you to start anew without reinstalling the game or losing access to DLC content. It’s a straightforward method built into the game’s settings, designed for players who crave a fresh start.
To reset your profile data, navigate to the game’s main menu and locate the *Settings* or *Options* tab. Depending on the version of *Spore* you’re using (PC, Mac, or console), the exact path may vary slightly. Look for a section labeled *Profile Management* or *Data Options*. Here, you’ll find a button or checkbox explicitly labeled *Reset Profile Data* or *Clear Progress*. Before confirming, the game will typically prompt a warning, emphasizing that this action is irreversible. Once initiated, all saved creations, badges, and progress will be erased, returning your profile to its default state.
While resetting your profile data is simple, it’s not a decision to take lightly. Unlike deleting individual creations, this process affects your entire account. If you’re unsure, consider backing up your saved files first. On PC, these are usually located in the *Documents/My Games/Spore* folder, where you can copy and store your *Spore* folder elsewhere. This way, if you change your mind, you can restore your progress without starting over. For console users, backing up save data may require external storage or cloud saves, depending on the platform.
One practical tip is to use profile resets as a tool for experimentation. For instance, if you’re a seasoned player looking to challenge yourself, reset your profile and impose self-restrictions, such as avoiding certain editors or focusing on a single creature type. Alternatively, if you’re introducing a friend to the game, a fresh profile ensures they experience the tutorial stages without spoilers. Resetting can also resolve minor glitches tied to corrupted save files, though this should be a last resort after troubleshooting other solutions.
In conclusion, resetting profile data in *Spore* is a powerful yet simple way to reclaim the game’s initial wonder. It’s ideal for players seeking a blank canvas, whether for creative exploration or technical troubleshooting. Just remember: this action is permanent, so proceed with caution and consider backups if you’re attached to your current progress. With a fresh profile, the universe is once again yours to shape.
Mold Spores and Eye Health: Uncovering Potential Risks and Symptoms
You may want to see also
Frequently asked questions
To edit your Spore profile, launch the Spore game, navigate to the main menu, and select "My Spore Page." From there, you can access and modify your profile details.
No, Spore does not allow users to change their usernames or display names once they are created. These are permanently tied to your account.
To update your profile picture, go to "My Spore Page," select "Edit Profile," and choose the option to change your avatar. You can upload a new image or select one from your in-game creations.
Yes, you can edit your profile bio by accessing "My Spore Page," clicking on "Edit Profile," and modifying the description field. Save your changes before exiting.
Yes, you can manage your creations by going to "My Spore Page," selecting the creation you want to remove, and choosing the option to delete or hide it from your profile.